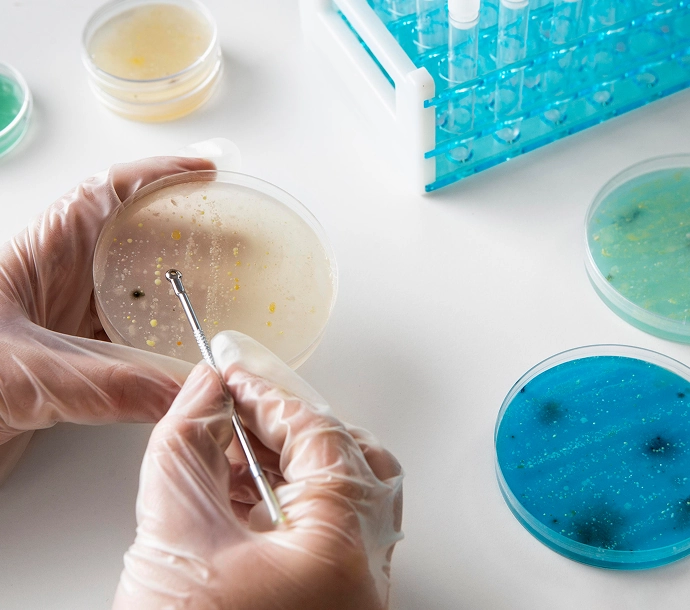
development image

Más de 30 años sirviendo en Aibonito con excelencia, humanidad y compromiso.
Con la misión de brindar servicios de salud confiables y de calidad.
Pacientes que han confiado en nosotros para su cuidado.
Pruebas realizadas con precisión y responsabilidad.
Más de tres décadas de servicio clínico nacen del compromiso y vocación de su fundadora, la Lcda. Janice Rolón Marrero. Hoy, Laboratorio Rolmar & Rolmar-Rivera Inc. siguen creciendo con la misma misión: servir con excelencia, respeto y humanidad.
Altamente calificados que lideran con innovación, precisión y compromiso.
Sucursal Principal Rolmar
202 Calle Julio Cintrón Suite 106, Aibonito PR 00705
Lunes a Viernes: 6:00 AM - 5:00 PM
Sábados y Feriados: 6:30 AM - 12:00 PM